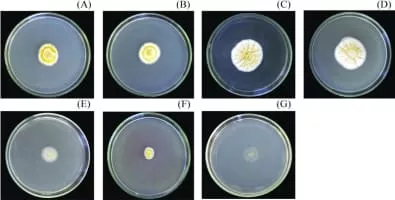
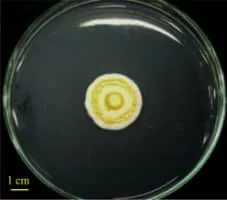

Aschersonia
| Use attributes for filter ! | |
| Scientific name | Aschersonia |
|---|---|
| Order | Hypocreales |
| Rank | Genus |
| Higher classification | Clavicipitaceae |
| Date of Reg. | |
| Date of Upd. | |
| ID | 1999308 |
About Aschersonia
Aschersonia is a genus of fungi in the order Hypocreales and family Clavicipitaceae.